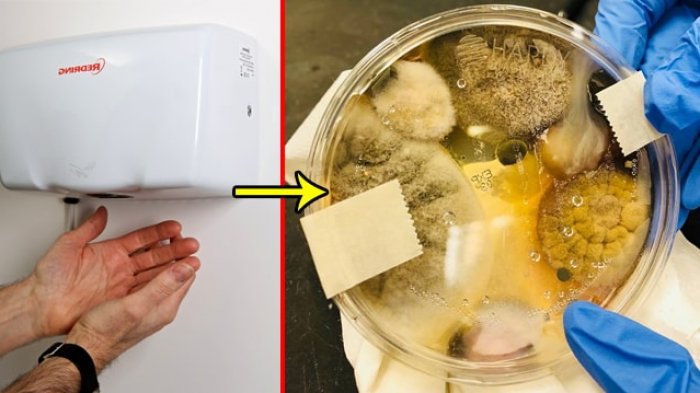

TRIBUNTRAVEL.COM - Selesai cuci tangan di toilet terkadang kita mengeringkan tangan menggunakan pengering.
Itu adalah cara praktis agar tangan cepat kering dalam sekejap.
Tapi traveler perlu tahu, dilansir dari nytimes.com, ada bahaya kesehatan yang mengancam saat seseorang menggunakan alat pengering tangan.
Para ilmuwan dari University of Leeds telah menemukan mesin pengering tangan atau 'jet-air dryer' justru dapat menyebarkan bakteri di toilet.
Studi ini menunjukkan kedua mesin pengering tangan berudara hangat mau pun dingin menyebar bakteri ke udara dan kepada para penggunanya.
Tim peneliti, yang dipimpin oleh Profesor Mark Wilcox dari School of Medicine, membuktikan tangan terkontaminasi dengan jenis berbahaya dari bakteri yang disebut Lactobacillus, yang tidak biasanya ditemukan di kamar mandi umum.
Deteksi berikutnya dari Lactobacillus di udara membuktikan, bakteri tersebut berasal dari tangan selama pengeringan.
Para ahli mengumpulkan sampel udara di sekitar pengering tangan pada jarak satu dan dua meter.
Jumlah bakteri dalam udara yang dekat dengan mesin pengering menjadi 4,5 kali lebih tinggi.
"Jika Anda mengeringkan tangan di toilet umum menggunakan mesin pengering tangan, Anda dapat menyebarkan bakteri tanpa menyadarinya.
Tangan mungkin juga akan berlumuran bakteri dari tangan orang lain.
Temuan ini penting untuk memahami cara bakteri menyebar, dan berpotensi untuk mengirimkan penyakit dan menimbulkan penyakit" kata Prof. Wilcox seperti yang dikutip dari nytimes.
Jurnal penelitian ini pernah dipublikasikan dalam Journal of Hospital Infection dan telah dipresentasikan di Healthcare Infection Society (HIS) International Conference di Lyon, France.
Meski mesin ini pasti akan lebih cepat dan efisien dalam mengeringkan tangan, kombinasi dari kelembapan dan kuman yang ada di udara kamar mandi, tangan Kita sendiri, dan udara hangat yang dihembuskan dari mesin akan mendorong bateri semakin giat berkembang biak.
Kuman dan virus berkembang dalam suhu hangat, terutama yang dekat dengan suhu tubuh.
Dilansir dari health.clevelandclinic.org, cara membersihkan tangan yang baik adalah:
* Gunakan air hangat atau dingin. Basahi tangan, lalu matikan keran, lalu oleskan sabun.
* Bersihkan dengan baik, cuci punggung tangan, di antara jari-jari dan di bawah kuku selama 20 detik
* Bilas dengan bersih yang mengalir.
* Keringkan tangan dengan handuk bersih atau udara bebas.
Berita ini telah dimuat di Nakita.grid.id dengan judul Tak Terduga, inilah Ancaman Kesehatan Dibalik Mesin Pengering Tangan